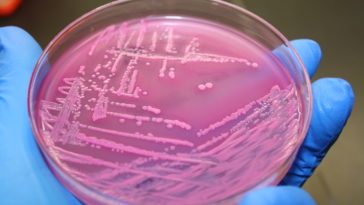
antibiotique e coli

Brice Louvet
Brice est un journaliste passionné de sciences. Ses domaines favoris : l'espace et la paléontologie. Il collabore avec Sciencepost depuis près d'une décennie, partageant avec vous les nouvelles découvertes et les dossiers les plus intéressants.